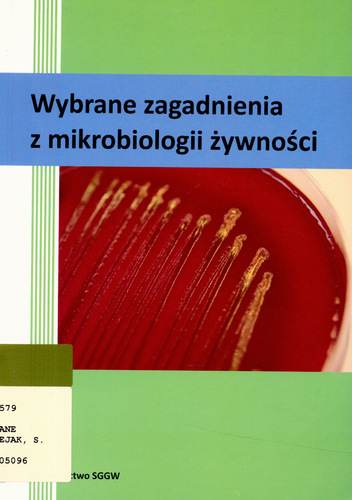

- Tytuł pełny:
- Ćwiczenia z mikrobiologii : podręcznik dla szkół wyższych / autorzy: Ewa Bieszkiewicz [i 14 pozostałych] ; komitet redakcyjny: Ludmiła Bassalik-Chabielska, Krystyna Kotełko, Tadeusz M. Lachowicz, Zbigniew Lorkiewicz ; koordynacja całości pracy Ludmiła Bassalik-Chabielska ; przedmowa Ludmiła Bassalik-Chabielska
- Wydawca:
- Warszawa : Państwowe Wydawnictwo Naukowe
- Wydanie:
- Wydanie I
- Rok wydania:
- copyright 1971
Książka